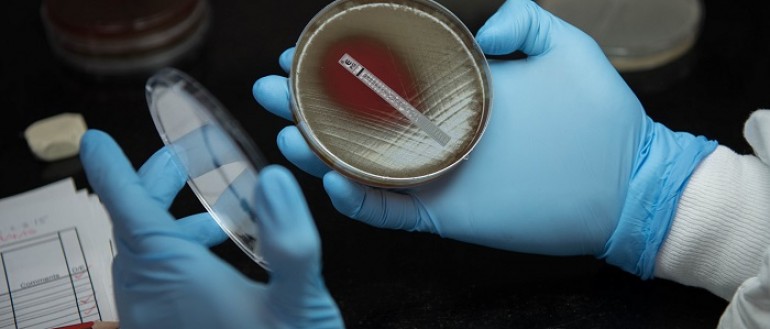

-

RESPOSTA - One Health Solutions for Timor-Leste and the region
Research Excellence and Surveillance to Promote One health Solutions for Timor-Leste And the region (RESPOSTA)
-

-

Australian Centre of Research Excellence in Malaria Elimination (ACREME)
ACREME is a network of leading malaria researchers dedicated to realising the goal of eliminating malaria in our region by 2030.
-

Targeted Approaches To Improve Cancer Services (TACTICS)
The Centre of Research Excellence (CRE) in Targeted Approaches To Improve Cancer Services (TACTICS) for Aboriginal and Torres Strait Islander People
-

-
CRE in Respiratory Health
Menzies’ CRE in Respiratory Health is dedicated to improving the lung health of children, particularly Indigenous children.